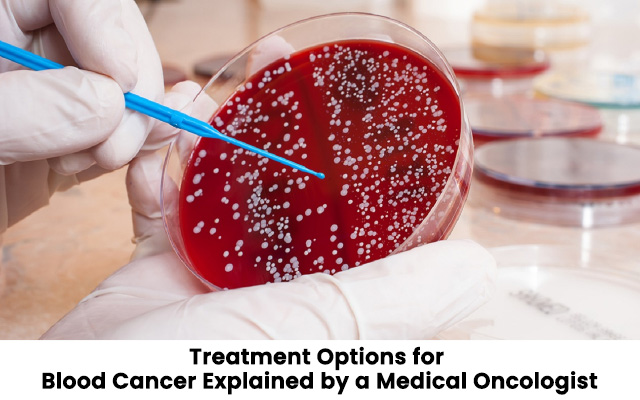
Treatment Options for Blood Cancer Explained by a Medical Oncologist

by drjoydghbfbo | Mar 26, 2025 | Blog
Blood cancer affects the blood, bone marrow, or lymphatic system. It includes types like leukaemia, lymphoma, and myeloma. Treating blood cancer can be complex due to the variety of subtypes and the individual needs of each patient. Treatments for Blood Cancer...

by drjoydghbfbo | Mar 12, 2025 | Blog
Chemotherapy is one of the most significant cancer treatments. But, it can cause some side effects in certain cases. Alongside chemotherapy, doctors are therefore exploring alternative therapies such as targeted therapy, immunotherapy and radiation therapy. These...